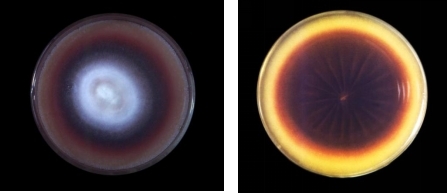

微信扫描二维码,点击右上角 ··· 按钮
转发给朋友或分享到朋友圈
显微镜带您认识藏在脚气里的“顽固分子”——红色毛癣菌
发布时间:2026-04-07
访问量:54
每到春夏,脚趾间瘙痒、脱皮、小水疱反复发作——这很可能是红色毛癣菌在作祟。作为脚气(足癣)最主要的致病菌,红色毛癣菌被称为皮肤癣菌中的“顽固分子”。它不仅难以根除,还常常“潜伏”在皮肤角质层中,伺机复发。
今天,我们就借助显微镜的视角,揭开这个顽固分子的真面目。
在显微镜下,红色毛癣菌有着独特的形态特征。经过乳酸酚棉蓝染色后,可以清晰地看到透明、有隔的菌丝,菌丝两侧生长着梨形或棒状的小分生孢子,有时可见细长、壁薄的大分生孢子。

在实验室培养条件下,红色毛癣菌在沙堡弱培养基上生长为绒毛状菌落,初期呈白色,成熟后逐渐转为红色或棕红色,背面常渗出深红色色素——这也是它名字的由来。
红色毛癣菌的顽固,体现在三个方面:
1. 潜伏能力强
它可以在皮肤上携带而不引起任何症状,处于潜伏感染状态。当环境适宜(如长时间穿鞋、足部潮湿)时,便迅速激活,导致脚气复发。这种“静默存在”的能力,让患者常常误以为脚气已经自愈,实则只是暂时休眠。
2. 生物被膜保护
研究发现,红色毛癣菌能够形成生物被膜——一种由菌丝和胞外基质组成的复杂结构,如同一道“物理屏障”,显著降低抗真菌药物的渗透效率。这解释了为什么单纯的外用药物有时难以彻底清除感染。
3. 角质层避难所
红色毛癣菌主要侵犯皮肤的角质层。当感染时间较长、角质层增厚后,外用药物难以渗透到病菌藏匿的深处,必须依赖口服药物才能触及。
在科研领域,倒置显微镜是研究红色毛癣菌的重要工具。
研究人员将红色毛癣菌接种到培养板中,在不同时间点用倒置显微镜观察生物被膜的形态变化——从最初的孢子黏附,到菌丝伸出,再到形成致密的被膜网络,每一个关键节点都被清晰记录。
当测试新型抗真菌药物(如异黄绵马酸PB、盐酸小檗碱)的效果时,显微镜下的变化更加直观:菌丝表面变粗糙、萎缩、皱瘪,出现破损和断裂,细胞结构模糊甚至崩解。这些形态学证据,为药物研发提供了最直接的视觉支撑。

在真菌研究与临床检验中,一台可靠的显微镜不可或缺。
明美光电倒置显微镜采用无限远光学系统与高性能平场物镜,能够清晰呈现红色毛癣菌的菌丝、孢子及生物被膜细节。无论是日常的真菌镜检(如KOH直接涂片观察),还是科研中的药物作用机制研究,明美显微镜都能提供高分辨率、高对比度的图像,帮助研究人员“看清”每一个顽固分子。
MIX60系列:适合临床检验室的日常真菌镜检,操作简便,成像清晰
MIX60-FL:配备荧光模块,可进行荧光染色观察,辅助真菌鉴定
MCS活细胞成像系统:支持培养箱内长时间动态监测,记录生物被膜形成全过程

红色毛癣菌虽顽固,但在显微镜的注视下,它的形态、结构、变化都无所遁形。从基础的KOH涂片镜检,到前沿的药物机制研究,显微镜始终是揭开这个“顽固分子”真面目的关键工具。
下一次脚痒难忍时,不妨想一想:那些看不见的菌丝,正在显微镜下等待着被揭穿。而选择一台可靠的倒置显微镜,就是为实验室配备了一双“火眼金睛”。
免责声明
本站无法鉴别所上传图片、字体或文字内容的版权,如无意中侵犯了哪个权利人的知识产权,请来信或来电告之,本站将立即予以删除,谢谢。
微信扫描二维码,点击右上角 ··· 按钮
转发给朋友或分享到朋友圈